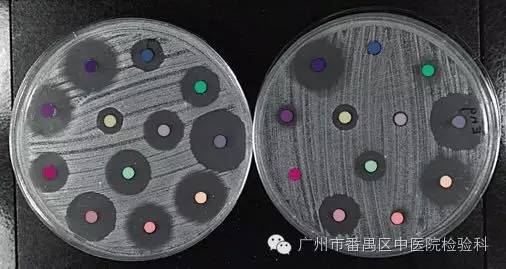

药物敏感试验简称药敏试验(或耐药试验)。旨在了解病原微生物对各种抗生素的敏感(或耐受)程度,以指导临床合理选用抗生素药物的微生物学试验。一种抗生素如果以很小的剂量便可抑制、杀灭致病菌,则称该种致病菌对该抗生素“敏感”。反之,则称为“不敏感”或“耐药”。为了解致病菌对哪种抗菌素敏感,以合理用药,减少盲目性,往往应进行药敏试验。




药物敏感试验简称药敏试验(或耐药试验)。旨在了解病原微生物对各种抗生素的敏感(或耐受)程度,以指导临床合理选用抗生素药物的微生物学试验。一种抗生素如果以很小的剂量便可抑制、杀灭致病菌,则称该种致病菌对该抗生素“敏感”。反之,则称为“不敏感”或“耐药”。为了解致病菌对哪种抗菌素敏感,以合理用药,减少盲目性,往往应进行药敏试验。